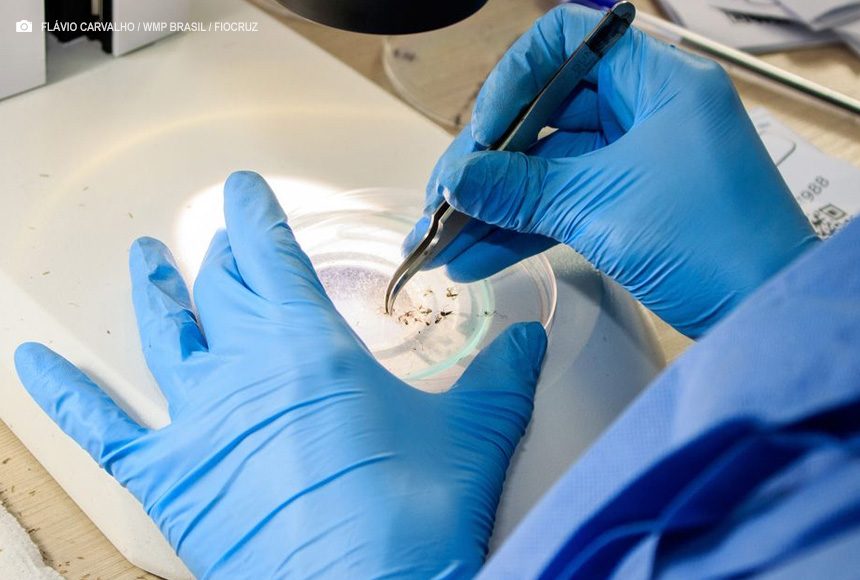

Por Paula Laboissière
O Ministério da Saúde e o governo de Minas Gerais inauguraram nesta segunda-feira (29), em Belo Horizonte, a Biofábrica Wolbachia. A unidade, administrada pela Fundação Oswaldo Cruz (Fiocruz), vai permitir ao Brasil ampliar sua capacidade de produção de uma das principais tecnologias no combate à dengue e outras arboviroses.
A Wolbachia é uma bactéria presente em cerca de 60% dos insetos na natureza, mas ausente naturalmente no Aedes aegypti. O chamado método Wolbachia consiste em inserir a bactéria em ovos do mosquito em laboratório e criar Aedes aegypti que portam o microrganismo. Infectados pela Wolbachia, eles não são capazes de carregar os vírus que causam dengue, zika, chikungunya ou febre amarela.
Esses mosquitos, apelidados de Wolbitos, quando se reproduzem, passam a bactéria para novos mosquitos, fazendo com que menos insetos possam transmitir doenças para os seres humanos.
“Estamos trabalhando em conjunto com o governo do estado [de Minas Gerais] para que possamos fazer com que essa fábrica possa expandir, não só para os 22 municípios que compõem a bacia de Brumadinho, mas para todos os municípios de Minas Gerais, depois do Brasil e da região das Américas”, disse a secretária de Vigilância em Saúde e Ambiente do ministério, Ethel Maciel.
“O Ministério da Saúde tem um plano de expansão. Esta é a primeira biofábrica, além da do Rio de Janeiro. Teremos [ainda] uma no Ceará, outra no Paraná e um plano de expansão para que a tecnologia desse mosquito, que tem uma bactéria que impede a transmissão da doença, possa então substituir a população de mosquitos que não têm a bactéria”, informou.
Experiência de Niterói
Em 2015, o método Wolbachia começou a ser implementado como projeto piloto em Niterói, no Rio de Janeiro. No ano passado, o município se tornou o primeiro no país com 100% do território coberto pelo método. Os números indicam redução de cerca de 70% dos casos de dengue, 60% de chikungunya e 40% de zika nas áreas onde houve a intervenção entomológica.
Em 2015, ano da implantação do projeto, foram confirmados 158 casos de dengue em Niterói. Em 2016, foram 71 e, em 2017, 87. Em 2018, houve aumento para 224 casos, mas o número caiu para 61 no ano seguinte. A partir de 2020, com 85 casos, a curva seguiu em queda, com 16 registros em 2021 e 12 em 2022. Em 2023, foram confirmados 55 casos de dengue na cidade.
Efeito de médio prazo
Desenvolvido na Austrália, o método Wolbachia é usado no Brasil porque o país é, desde 2014, um dos 11 países que compõem o Programa Mundial de Mosquitos. No Brasil, a iniciativa é conduzida pela Fiocruz, com financiamento do ministério em parceria com governos locais. Atualmente, estão incluídas na pesquisa as cidades de Campo Grande, Petrolina (PE), Belo Horizonte, Niterói (RJ) e Rio de Janeiro.
Ainda neste ano, o método deve chegar a mais seis cidades: Natal, Uberlândia (MG), Presidente Prudente (SP), Londrina e Foz do Iguaçu, ambas no Paraná, e Joinville (SC). A tecnologia, no entanto, não tem resultado imediato e precisa ser associada a outras ações para combater as doenças transmitidas pelo Aedes aegypti.
A cidade do Rio de Janeiro, por exemplo, apesar de ter recebido o método Wolbachia, está em situação diferente da de Niterói e chegou a declarar situação de emergência por causa do aumento de internações por suspeita de dengue. No Rio, o Wolbito foi liberado apenas em algumas regiões, e não em toda a cidade, como em Niterói.